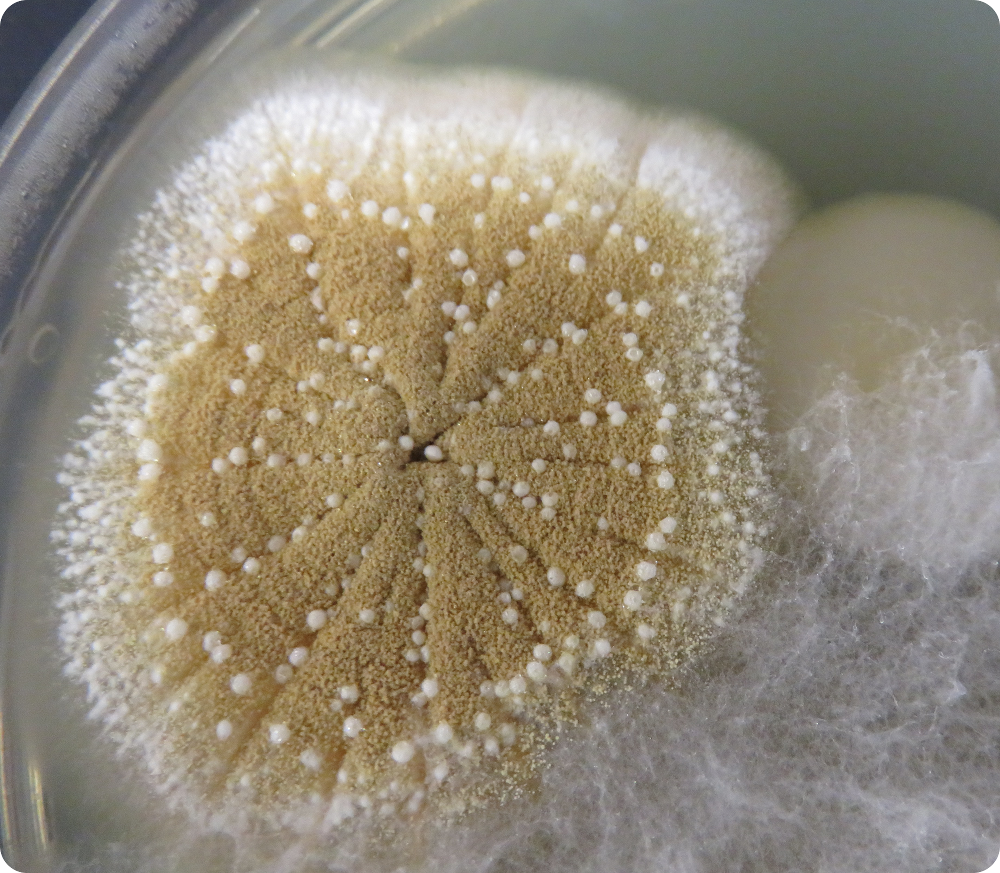
FloralMicrobe

Keywords: learning and memory, specialization, costs of learning, chemical ecology, coevolution, pollen, foraging, buzz pollination, floral sonication, multimodal cues, complex signals, pollinator cognition, microbes

2019 wordle of our publication abstracts
Flower and pollinator microbes
“Everything is everywhere, but the environment selects”. Microscopic organisms, such as bacteria and fungi, live in association with flowers and their pollinators.
“Everything is everywhere, but the environment selects”. Microscopic organisms, such as bacteria and fungi, live in association with flowers and their pollinators.
We are just now beginning to understand how microbes interact with their pollinator and flower hosts. Yet little is known about how microbes affect plant-pollinator relationships.
We study how pollinator behavior and cognition affects microbial dispersal, and how microbes manipulate pollinator behavior and floral display traits.
Learning of floral display traits

The incredible diversity of flowers is often ascribed to learned pollinator behavior. Flowers offer rewards to manipulate pollinators; pollen (the male gamete) and nectar are the most common floral rewards. Protein-rich pollen and carbohydrate-rich nectar are nutritionally complementary.
Yet more than a century of research on pollinator cognition has been conducted nearly exclusively within the context of floral nectar rewards.
We investigate the complex signals, floral cues and structures learned by pollinators in a pollen foraging context and consequences for floral display evolution.
Pollen extraction behavior
 Flowers offering pollen rewards vary greatly in floral form. Most species present their pollen openly, to varying degrees, on the surfaces of their anthers. Fully 6% of flowering plant species conceal their pollen within specialized tubular (“poricidal“) floral structures.
Flowers offering pollen rewards vary greatly in floral form. Most species present their pollen openly, to varying degrees, on the surfaces of their anthers. Fully 6% of flowering plant species conceal their pollen within specialized tubular (“poricidal“) floral structures.
Plant species that conceal their pollen are nearly exclusively pollinated by bees, which shake the pollen out by buzzing (“floral sonication“) violently at more than 20Gs.
 Conversely, bees typically collect pollen from plant species that expose their pollen by using their legs and mouth parts to knock the pollen off – a behavior termed scrabbling.
Conversely, bees typically collect pollen from plant species that expose their pollen by using their legs and mouth parts to knock the pollen off – a behavior termed scrabbling.
We study how bees adjust to extract pollen efficiently from flowers of varying morphology, floral cues that regulate efficient pollen extraction, the evolution of pollen extraction behavior, and consequences for plant fitness and floral evolution.
Constraints of reward specialization

There are more than 20,000 bee species world-wide.
Less than 10% are social; living in groups. The females of solitary bees must provision their young with nectar and pollen on their own. Bees living in groups though could specialize on a flowering species, or even on a particular floral reward.
Why specialize? Instead of spending time and energy learning how to collect two food types, the bee would only have to learn one.
We study why bees specialize on pollen versus nectar, timescales of specialization, advantages to specialization, and the evolution of specialization.
All photos copyright Avery Russell